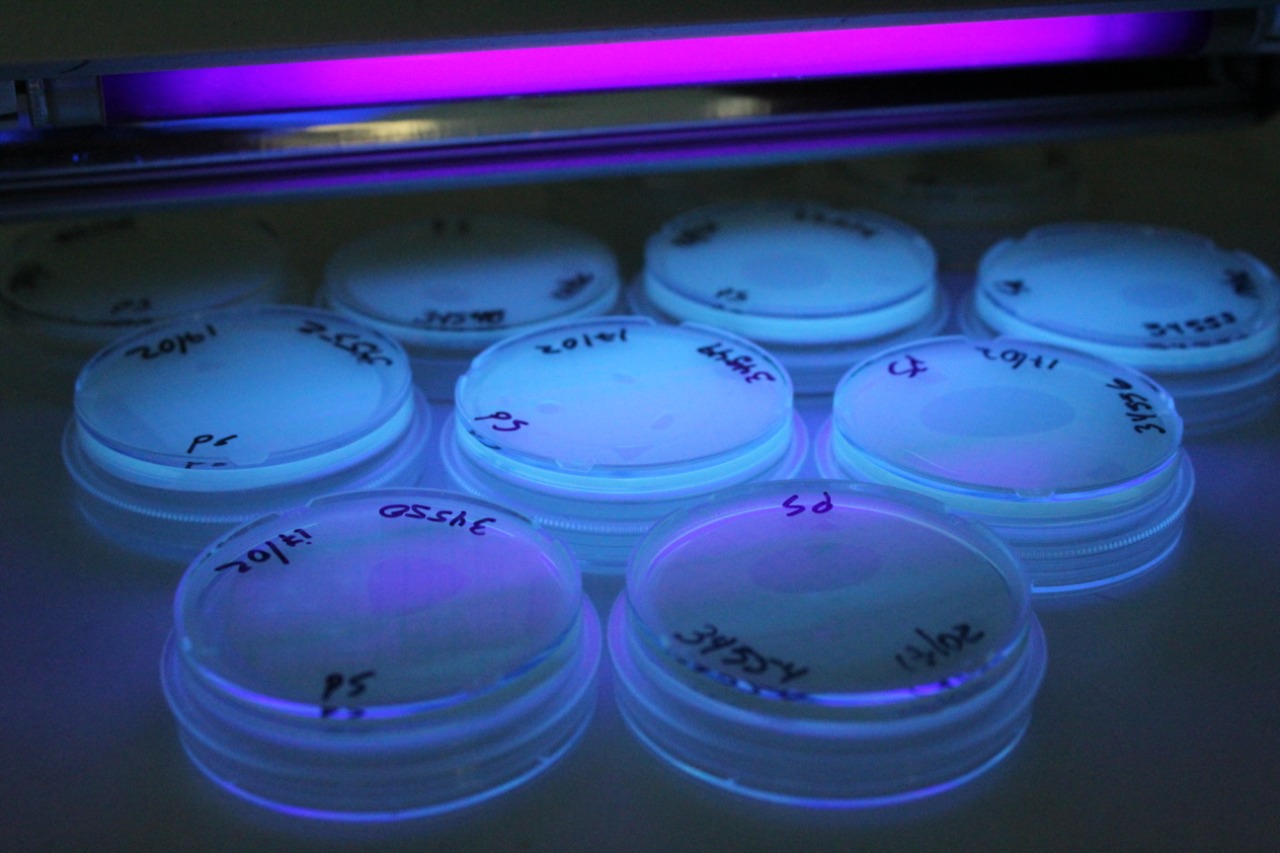

En nuesto Laboratorio de Microbiología realizamos una gran variedad de análisis microbiológicos para la preservación y cuidado de la salud, enfocados en satisfacer las necesidades del mercado dominicano, ayudando a las empresas productoras de consumo nacional y exportadoras en el aseguramiento de la inocuidad de sus alimentos. Tramitación de permisología para productos agrícolas de exportación según las regulaciones de la FDA (Imprt Alert 99-14).Nuestro servicio se desarrolla bajo la implementación de reconocidas metodologías, sustentadas en un sistema de gestión de calidad garantizado de acuerdo a los requerimientos y necesidades de nuestros clientes.
Practicamos análisis de microbiología de alimentos, equipos y utensilios ayudando a la prevención y evitar la propagación de contaminantes, mejorando la ejecución de prácticas adecuadas de producción que garantizan calidad en los productos.
Análisis y Servicios
- Pruebas de Esterilidad de Productos Farmacéuticos
- Muestreos Microbiológicos de Ambiente y Superficies
- Evaluación de Cuartos Limpios
- Aerobios Mesófilos
- Candida
- Coliformes Fecales FM
- Coliformes Fecales NMP
- Coliformes Totales FM
- Coliformes Totales NMP
- E. Coli FM
- E. Coli 0157:H7
- Enterococcus
- Legionella
- Listeria sp.
- Listeria Monocytogenes
- Mohos y Levaduras
- Pseudomona Aeruginosa
- Salmonella sp. MDS
- Staphylococcus Aureus


 " data-bg="c:#060066;" class="rev-slidebg" data-no-retina>
" data-bg="c:#060066;" class="rev-slidebg" data-no-retina>

" class="rev-slidebg" data-no-retina>
" class="rev-slidebg" data-no-retina>  " class="rev-slidebg" data-no-retina>
" class="rev-slidebg" data-no-retina>  " class="rev-slidebg" data-no-retina>
" class="rev-slidebg" data-no-retina>  " class="rev-slidebg" data-no-retina>
" class="rev-slidebg" data-no-retina>  " class="rev-slidebg" data-no-retina>
" class="rev-slidebg" data-no-retina>  " class="rev-slidebg" data-no-retina>
" class="rev-slidebg" data-no-retina>  " class="rev-slidebg" data-no-retina>
" class="rev-slidebg" data-no-retina>  " class="rev-slidebg" data-no-retina>
" class="rev-slidebg" data-no-retina>  " class="rev-slidebg" data-no-retina>
" class="rev-slidebg" data-no-retina>  " class="rev-slidebg" data-no-retina>
" class="rev-slidebg" data-no-retina>  " class="rev-slidebg" data-no-retina>
" class="rev-slidebg" data-no-retina>  " class="rev-slidebg" data-no-retina>
" class="rev-slidebg" data-no-retina>  " class="rev-slidebg" data-no-retina>
" class="rev-slidebg" data-no-retina>  " class="rev-slidebg" data-no-retina>
" class="rev-slidebg" data-no-retina>  " class="rev-slidebg" data-no-retina>
" class="rev-slidebg" data-no-retina>  " class="rev-slidebg" data-no-retina>
" class="rev-slidebg" data-no-retina>  " class="rev-slidebg" data-no-retina>
" class="rev-slidebg" data-no-retina>  " class="rev-slidebg" data-no-retina>
" class="rev-slidebg" data-no-retina>  " class="rev-slidebg" data-no-retina>
" class="rev-slidebg" data-no-retina>  " class="rev-slidebg" data-no-retina>
" class="rev-slidebg" data-no-retina>